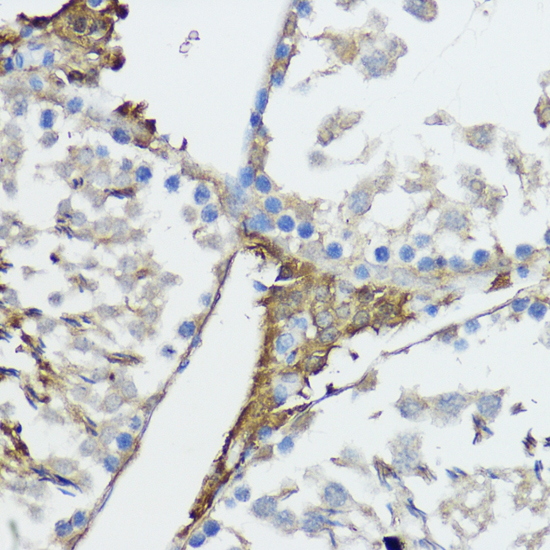
Immunohistochemistry - NOD1 Polyclonal Antibody

-
Product Name
NOD1 Polyclonal Antibody
- Documents
-
Description
Polyclonal antibody to NOD1
-
Tested applications
WB, IHC
-
Species reactivity
Human, Mouse, Rat
-
Alternative names
NOD1 antibody; CARD4 antibody; CLR7.1 antibody; NLRC1 antibody; nucleotide binding oligomerization domain containing 1 antibody
-
Isotype
Rabbit IgG
-
Preparation
Antigen: Recombinant fusion protein containing a sequence corresponding to amino acids 1-270 of human NOD1 (NP_006083.1).
-
Clonality
Polyclonal
-
Formulation
PBS with 0.02% sodium azide, 50% glycerol, pH7.3.
-
Storage instructions
Store at -20℃. Avoid freeze / thaw cycles.
-
Applications
WB 1:500 - 1:2000
IHC 1:50 - 1:200 -
Validations

Western blot - NOD1 Polyclonal Antibody
Western blot analysis of extracts of various cell lines, using NOD1 antibody at 1:1000 dilution.Secondary antibody: HRP Goat Anti-Rabbit IgG (H+L) at 1:10000 dilution.Lysates/proteins: 25ug per lane.Blocking buffer: 3% nonfat dry milk in TBST.Detection: ECL Basic Kit .Exposure time: 120s.

Immunohistochemistry - NOD1 Polyclonal Antibody
Immunohistochemistry of paraffin-embedded human mammary cancer using NOD1 antibody at dilution of 1:100 (40x lens).

Immunohistochemistry - NOD1 Polyclonal Antibody
Immunohistochemistry of paraffin-embedded human liver cancer using NOD1 antibody at dilution of 1:100 (40x lens).

Immunohistochemistry - NOD1 Polyclonal Antibody
Immunohistochemistry of paraffin-embedded rat ovary using NOD1 antibody at dilution of 1:100 (40x lens).
Immunohistochemistry - NOD1 Polyclonal Antibody
Immunohistochemistry of paraffin-embedded rat testis using NOD1 antibody at dilution of 1:100 (40x lens).

Immunohistochemistry - NOD1 Polyclonal Antibody
Immunohistochemistry of paraffin-embedded mouse kidney using NOD1 antibody at dilution of 1:100 (40x lens).
-
Background
Enhances caspase-9-mediated apoptosis. Induces NF-kappa-B activity via RIPK2 and IKK-gamma. Confers responsiveness to intracellular bacterial lipopolysaccharides (LPS). Forms an intracellular sensing system along with ARHGEF2 for the detection of microbial effectors during cell invasion by pathogens. Required for RHOA and RIPK2 dependent NF-kappa-B signaling pathway activation upon S.flexneri cell invasion. Involved not only in sensing peptidoglycan (PGN)-derived muropeptides but also in the activation of NF-kappa-B by Shigella effector proteins IpgB2 and OspB. Recruits NLRP10 to the cell membrane following bacterial infection.
Related Products / Services
Please note: All products are "FOR RESEARCH USE ONLY AND ARE NOT INTENDED FOR DIAGNOSTIC OR THERAPEUTIC USE"
